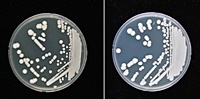
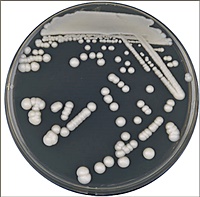

오늘은 맥주효모의 효능과 부작용에 대해 알아보겠습니다. 최근 맥주 양조의 부산물인 맥주효모가 건강식품으로 주목받고 있습니다. 맥주효모는 맥주가 발효되는 과정에서 얻어지는 효모로, 맥아로 만든 맥즙을 발효시켜 만들어집니다.
맥주효모
효모는 물, 보리, 홉과 함께 맥주를 만드는 네 가지 주요 재료 중 하나입니다. 빵을 만들 때 사용하는 효모는 '이스트'라고 부르며, 이는 빵이 부풀어 오르는 발효 효과를 담당합니다. 맥주효모는 맥주 양조 과정에서 맥즙을 발효시켜 알코올과 탄산을 생성하는데, 이때 사용되는 사카로미세스 세레비시아(Saccharomyces cerevisiae) 효모가 바로 맥주효모입니다.
맥주효모는 동물이 합성할 수 없는 필수아미노산, 비타민 B군, 미네랄, 식이섬유, 철분 등 다양한 영양소를 풍부하게 포함한 건강식품입니다.
맥주효모의 효능
맥주효모의 효능 1. 탈모방지
맥주효모에는 모발을 생성하는 데 필요한 단백질과 시스틴, 비오틴, 메티오닌, 비타민 B군 등이 풍부하게 들어있습니다. 이 성분들은 모발 건강을 유지하고 탈모를 예방하는 데 중요한 역할을 합니다. 또한, 맥주효모에 포함된 아연은 탈모의 원인인 DHT 생성을 억제하는 효소를 효과적으로 차단합니다.
맥주효모의 효능 2. 면역력 보강
맥주효모에는 베타글루칸이라는 성분이 포함되어 있어, 면역 세포를 활성화하는 데 도움을 줍니다. 이 성분은 면역력을 강화하고 바이러스 감염을 예방하는 데 중요한 역할을 합니다. 또한, 맥주효모에는 노화 방지와 면역력 증강에 도움을 주는 핵산도 다량 포함되어 있습니다.
맥주효모의 효능 3. 위장 기능 개선
맥주효모는 소화에 도움을 주고 장내 환경을 개선하는 효과가 있습니다. 꾸준히 섭취하면 위장 건강에 도움이 될 수 있으며, 식욕을 증진시키고 신진대사를 촉진하는 데 기여합니다.
맥주효모의 효능 4. 여름 두피 건강
맥주효모에는 필수아미노산이 풍부하게 포함되어 있어 모발 건강에 좋습니다. 필수아미노산은 모발을 구성하는 단백질인 케라틴 생성에 중요한 영양소로, 두피 건강을 향상시키는 데 기여합니다.
맥주효모의 효능 5. 변비 개선
맥주효모는 식이섬유가 풍부해 장내 환경을 개선하고 자연스러운 배변을 촉진하는 데 도움을 줍니다. 이는 특히 변비로 고생하는 사람들에게 유익합니다.

맥주효모의 효능 6. 혈당조절
맥주효모에 포함된 비오틴은 인슐린 기능을 향상시켜 혈당 대사를 촉진하는 데 도움을 줍니다. 이는 당뇨병 예방에도 기여할 수 있습니다.
맥주효모의 효능 7. 장 건강
맥주효모는 장내 연동 운동을 촉진하고 대장을 부드럽게 하여 장 건강을 개선하는 데 기여합니다.
맥주효모의 효능 8. 에너지 증가
맥주효모는 천연 뉴클레오티드를 포함하고 있어 에너지 부스팅 효과를 제공합니다. 이는 운동 선수들의 지구력과 회복을 도와주는 데 유익합니다.
맥주효모의 효능 9. 간 건강
맥주효모는 간을 보호하는 셀레늄이 풍부하게 포함되어 있으며, 간질환 예방과 간 건강 회복에 도움을 줍니다.

맥주효모의 효능 10. 노화 방지
맥주효모에 포함된 비타민 B군과 미네랄은 신진대사를 활발하게 하고 항산화 작용을 통해 노화를 예방하는 데 도움을 줍니다.
맥주효모의 효능 11. 소화 기능 개선
맥주효모는 소화를 돕는 효소를 풍부하게 포함하고 있어 소화불량을 개선하고 신진대사를 촉진하는 데 효과적입니다.
맥주효모의 효능 12. 모유 수유에 적합
맥주효모는 모유 수유를 촉진하는 데 도움을 줄 수 있습니다. 그러나 섭취 시 설사나 복통 등의 부작용이 있을 수 있으므로 주의가 필요합니다.









맥주효모의 효능 13. 피부미용
맥주효모는 피부미용에도 유익하며, 노폐물과 독소를 제거하는 데 도움을 줍니다. 이는 피부를 진정시키고 건강하게 유지하는 데 기여합니다.
맥주효모의 단점
맥주효모는 탈모 예방, 면역력 보강, 손발톱 보강, 콜레스테롤 개선 등 여러 장점이 있지만, 과다 섭취 시 소화불량이나 설사 등의 부작용이 발생할 수 있습니다. 또한, 통풍 환자에게는 퓨린 성분이 포함되어 있어 주의가 필요합니다. 복용 중인 약이 있거나 질환이 있는 경우, 의사와 상담 후 섭취하는 것이 좋습니다.
오늘은 이렇게 맥주효모의 효능 13가지를 알아보았습니다. 도움이 되셨기를 바랍니다. 감사합니다.









갑상선 결절 원인 증상 예방방법
갑상선 결절은 갑상선 세포의 과증식으로 인해 특정 부분이 커지면서 혹을 형성하는 질환입니다. 이 질병은 상대적으로 자주 보이는 내분비 질환으로, 여성에게서 더 자주 발생한다고 합니다.
bluenote235.manythings.co.kr